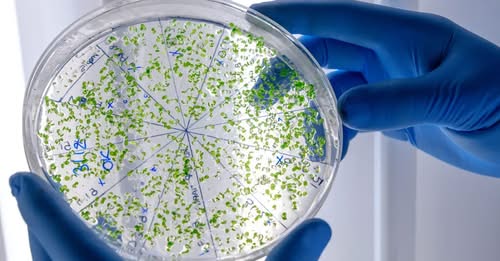

Komment - Teljes terjedelmében nyilvános a Tisza adóterve
Márki-- Zay Péter Hódmezővásárhely polgármestere
Molnár Zsolt az MSZP országgyűlési képviselője
Szűcs Gábor az Alapjogokért Központ szakértője, a…

A kormánypártok kommunikációs igazgatója tiszta vizet öntött a pohárba a brüsszeli szándékokról. Menczer Tamás szerint a képlet egyszerű: mivel a kormány nemet mond a háborúra, Brüsszel egy irányított bábkormányt akar a helyére ültetni, amelynek élére már ki is jelölték a "fogott embert".
Cikkünk a kommentek közt.
 : Cseh Gábor
: Cseh Gábor
Komment - Teljes terjedelmében nyilvános a Tisza adóterve
Márki-- Zay Péter Hódmezővásárhely polgármestere
Molnár Zsolt az MSZP országgyűlési képviselője
Szűcs Gábor az Alapjogokért Központ szakértője, a…
Gulyás Gergely: Földrajzi realitás, hogy az oroszoktól vásárolunk
Magyarországnak gazdasági- és földrajzi szempontból is az orosz energiahordozók a legmegfelelőbbek.
A városvezetés most már kénytelen szembenézni a valósággal.


Az AI játékok elveszik a gyerekek képzelőerejét
Csőre Gábor nézőpontja a modern gyerekjátékokról.